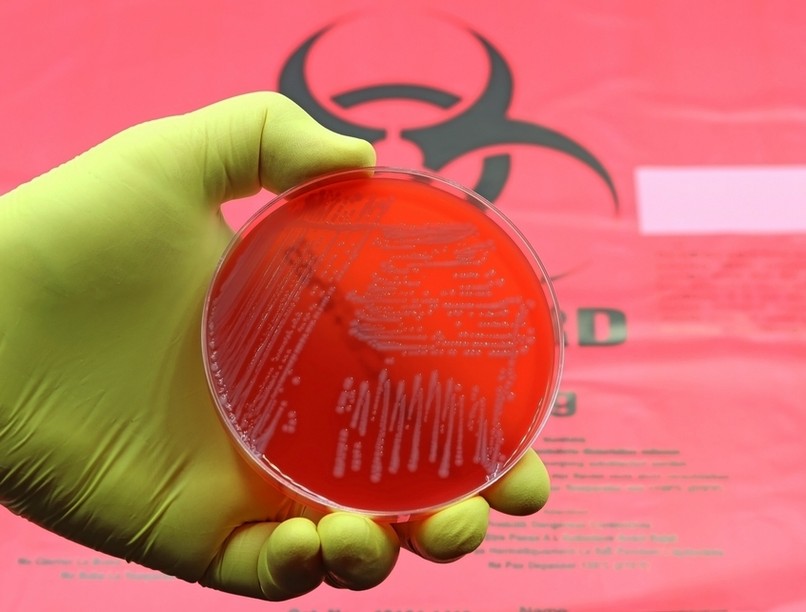
Acinetobacter baumannii antibiotikum rezisztencia AI

Áttörésnek is tekinthető eredmény született az AI-nak köszönhetően. Többé már nem lesz szükség kutatókra?
Több ezer potenciális gyógyszermolekula közül mesterséges intelligencia alkalmazásával sikerült kiválasztani azt az egyet, amely célzottan és hatásosan léphet fel a jövőben az Acinetobacter baumannii okozta életveszélyes fertőzésekkel szemben. A vegyület neve abaucin.
Valóban gyógyszereket hozhat létre a mesterséges intelligencia?
A hír igaz, a mesterséges intelligencia életeket mentő gyógyszerek megalkotására is használható. A tudományos áttörésnek is tekinthető eredményről tájékoztató közlemény a neves Nature szakfolyóiratban jelent meg, a szerzők USA-beliek, a híres MIT és a McMaster University munkatársai.
A hír két szempontból is mérföldkőnek számít. Egyrészt, rámutat arra, hogy a mesterséges intelligencia (artificial intelligence, AI) milyen lényeges szerepet kaphat a gyógyszerkutatásban, másrészt pedig bővülhet az antibiotikumok sora.
Ez utóbbi kiemelten fontos napjainkban, amikor a bakteriális rezisztencia széles körű térnyerése miatt egyre több antibiotikum válik hatástalanná. Az új antibiotikumok iránt hatalmas igény mutatkozik. Elegendő csupán azt az aggodalomra okot adó tényt említeni, miszerint a rezisztens bakteriális fertőzések évente körülbelül 5 millió emberéletet követelnek világszerte; és a tragikus következmények alól a fejlett országok sem kivételek.
A baktérium, amely ellen a mesterséges intelligenciát is bevetették
Az Acinetobacter baumannii (A. baumannii) egy Gram-negatív baktérium, amely tüdőgyulladást, meningitist és egyéb súlyos fertőzéseket okozhat. A baktérium maga rendkívül szívós, és ajtókilincseken vagy eszközök felületén hosszú ideig életképes marad.
Nem véletlen, hogy számtalan kórházi fertőzés hátterében is ez a kórokozó áll. Emellett, ez a baktérium a felelős az Irakban és Afganisztánban megsebesült katonák fertőzéseinek jelentős részéért is. Mint a Nature folyóiratban publikált közlemény szerzője, Jonathan Stokes mondja, az A. baumannii „No. 1 közellenség”. Mindeközben az A. baumannii egyre több, korábban és jelenleg is használt antibiotikummal szemben válik rezisztenssé, így lassanként nem lesz „fegyver” a kezünkben a vele szembeni harcban.
Így született meg az abaucin
Az A. baumannii elleni antibiotikum kiválasztásához ún. gépi tanulási folyamatot alkalmaztak. A gépi tanulás az a folyamat, amely során az AI magát tanítja adatok és tapasztalat alapján. Jelen esetben 7500 kémiai vegyületet képletét és főbb fizikai-kémiai adatait táplálták be a számítógépbe, illetve azt az információt, hogy – laboratóriumi kísérletek alapján – az adott vegyület képes-e az A. baumanni növekedésének gátlására vagy sem. Vagyis az AI „megtapasztalhatta” azt, hogy milyen kémiai struktúra és milyen sajátosságok bizonyulnak a leginkább hatékonynak az A. baumannii-val szemben.
Ezután egy 6680 különféle kémiai vegyületből álló listát zúdítottak az AI-re, amely a „tapasztalatai” alapján ezek közül kiválasztotta azokat, amely a legalkalmasabbnak bizonyulnak az A. baumannii ellen. A 240 legjobbnak bizonyult javasolt vegyületet a kutatók laboratóriumi körülmények között letesztelték, és az egyikük különösen hatásosnak és szelektív hatásúnak bizonyult; ez volt az abaucin. Érdekesség, hogy az abaucint eredetileg cukorbetegség kezelésére tervezték (a kutatók, nem a mesterséges inetlligencia).
Abaucin: szelektív hatás az A. baumannii ellen
Az abaucin nemcsak, hogy az A. baumannii növekedését és szaporodását gátolja, de a hatása szelektívnek is bizonyul az A. baumannii baktériummal szemben. Mindez azért lényeges, mert a valós életben egy antibiotikum-kezelés során a cél az, hogy a kórokozó baktérium elpusztuljon, ugyanakkor a többi bélbaktérium (nagyrészt jótékony bélbaktériumok) minél kisebb mértékű károsodást szenvedjen.
Vagyis, a terápiás célt követve az ideális antibakteriális hatóanyag az adott baktérium ellen hatásos, miközben a többi baktériumra, a bélflórára nincs vagy alig van hatással. Úgy tűnik, hogy az abaucin – mint az A. baumanni lipoproteinjeit szelektíven támadó hatóanyag – eleget tesz ezeknek a kritériumoknak.
Itt az AI, már nem lesz szükség kutatókra?
Sokan attól tartanak, hogy a mesterséges intelligencia „átveszi az irányítást az ember felett”. Mint azt a jelen példa is mutatja, a mesterséges intelligenciát az ember működteti, az ember nélkül nincs gépi tanulás, az ember nélkül nincs eredmény-kiértékelés.
Vagyis, a mesterséges intelligencia nyújtotta előnyök csak az emberi gondolkodás és tudás segítségével kamatoztathatók. Tény azonban, hogy okosan élve az AI nyújtotta lehetőségekkel, az AI jelentősen képes felgyorsítani és pontosabbá tenni a folyamatokat a gyógyszerkutatás területén is.
(via)
Olvasta már?
- Bonyolult feladatokat is gyorsan old meg? Kiderült, ez nem az intelligencia jele
- Mekkora a nyugalmi testhője? Meglepő, de ez is befolyásolhatja a súlyát
- Beazonosították a migrént kiváltani képes hétköznapi szagokat
Hogyan működik a sugárterápia? Ennyit fejlődött a feltalálása óta!
Kövesse az Egészségkalauz cikkeit a Google Hírek-ben, a Facebook-on, az Instagramon vagy a X-en,Tiktok-on is!